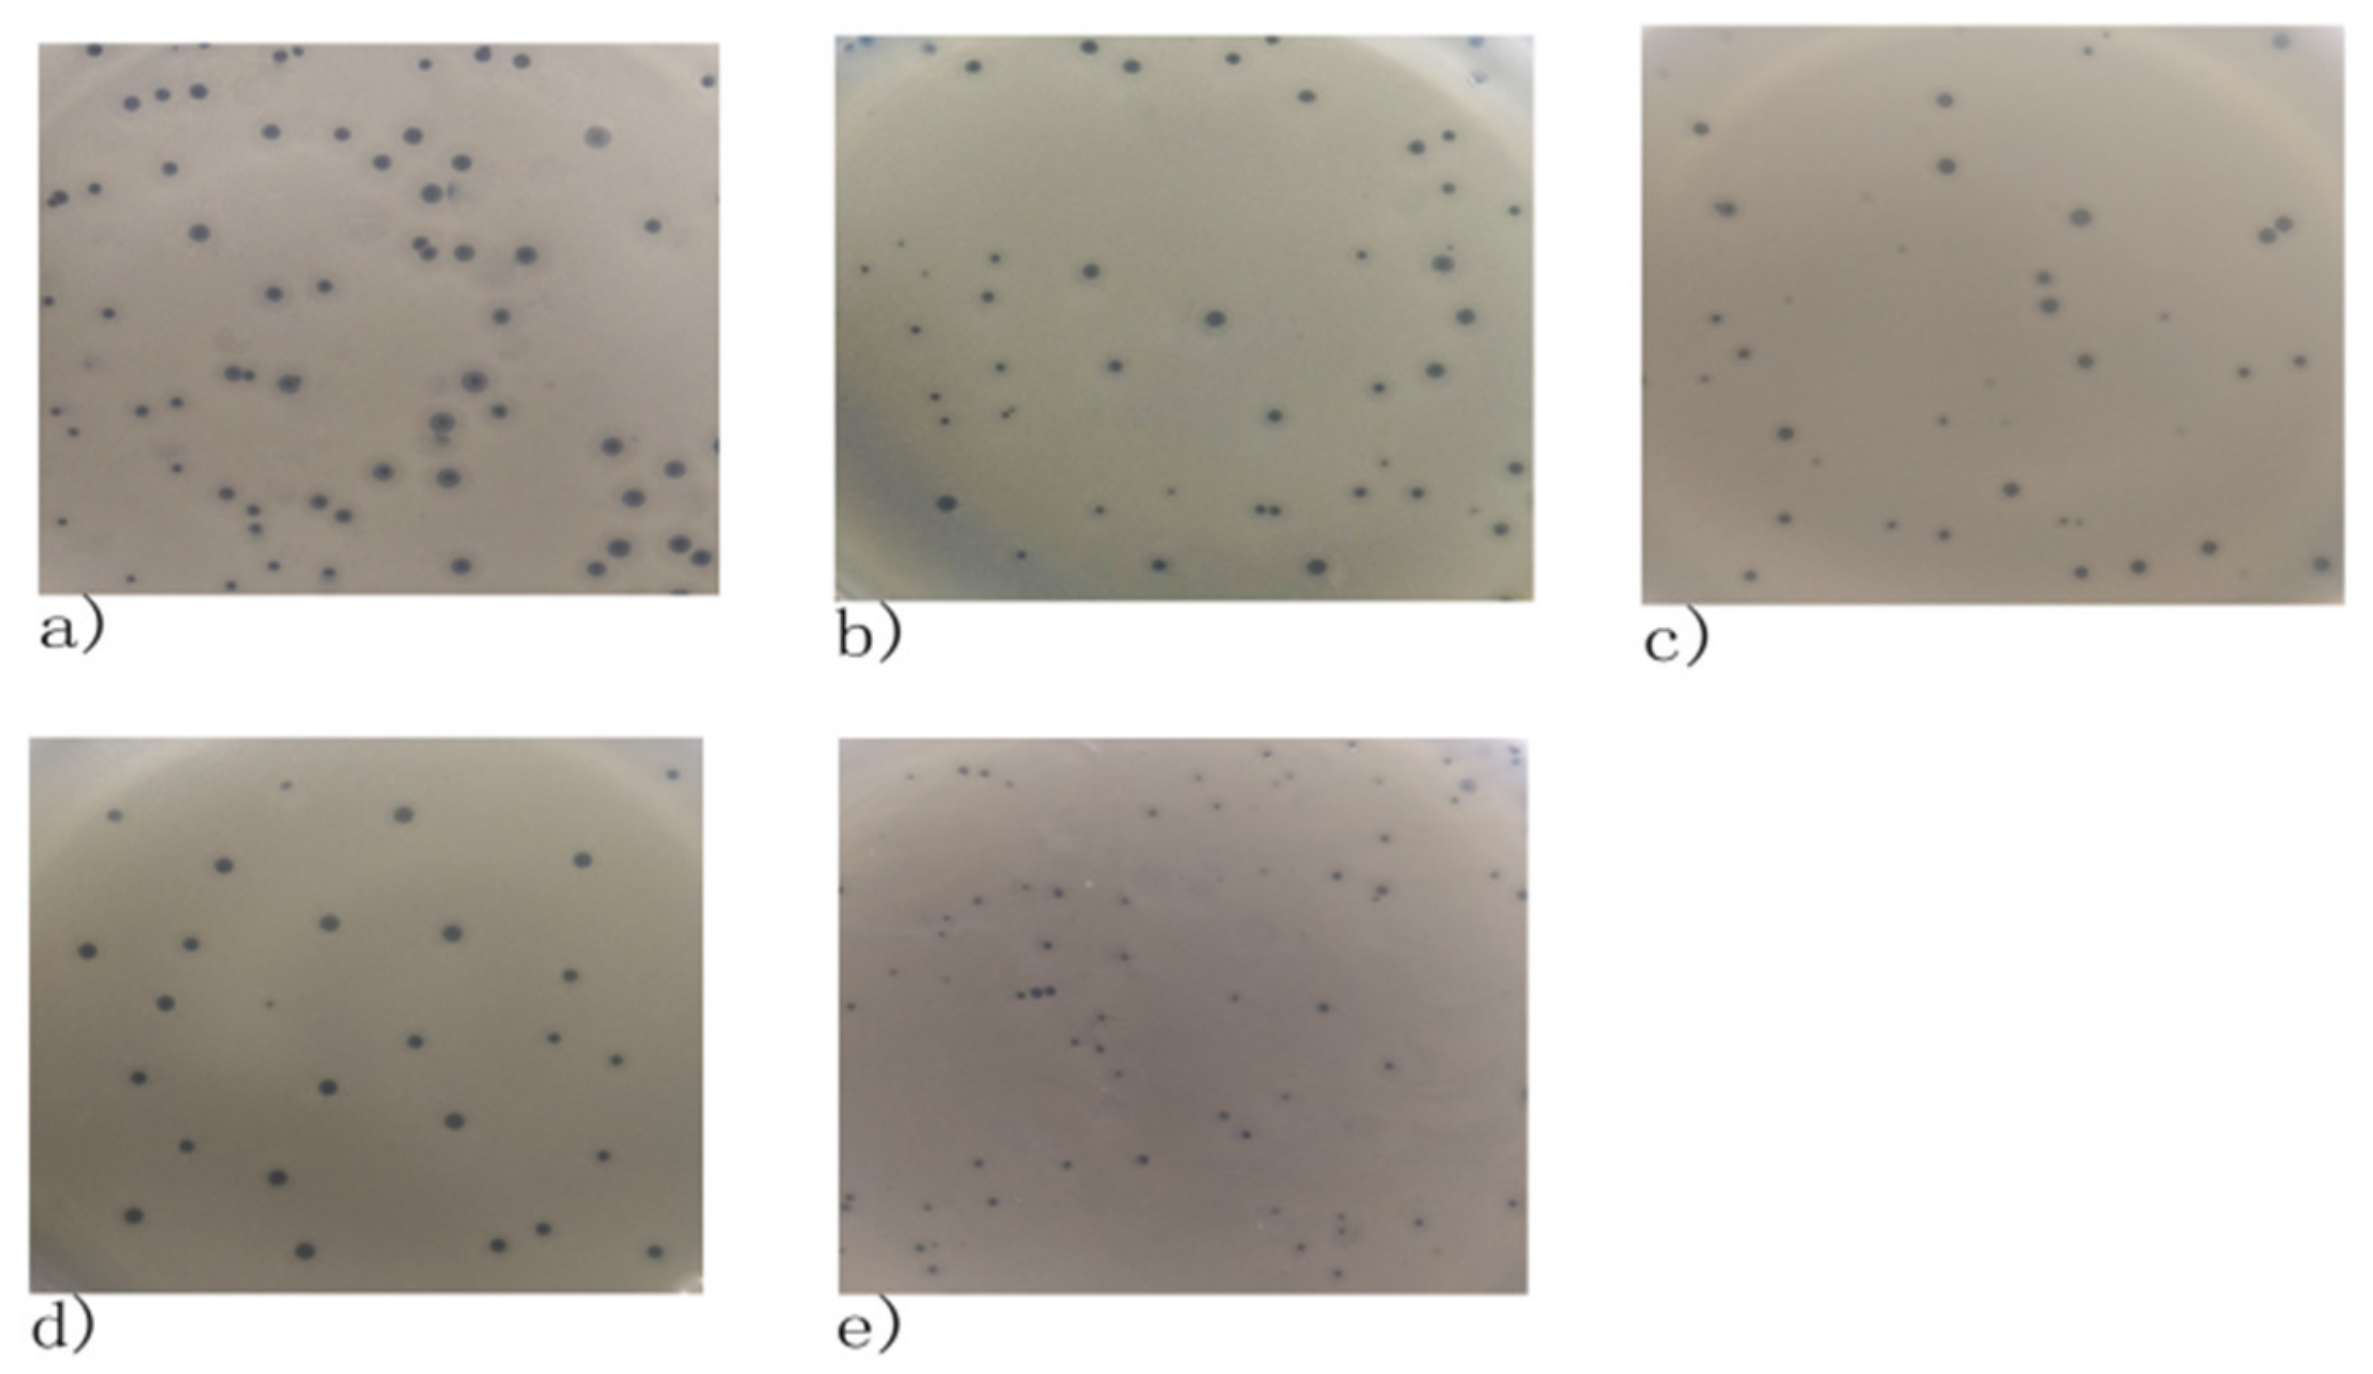
Viruses 14 00620 g001

Efficacy Assessment of Phage Therapy in Treating Staphylococcus aureus-Induced Mastitis in Mice
Abstract
:1. Introduction
2. Materials and Methods
2.1. Bacterial Strains
2.2. Phage Isolation and Culture Conditions
2.3. Transmission Electron Microscopy
2.4. Spot Test
2.5. Optimal Multiplicity of Infection
2.6. One-Step Growth Curve
2.7. DNA Extraction and Identification
2.8. Growth Kinetic Curve of In Vitro Lysis
2.9. Detection of Phages to Remove Biofilms
2.10. Infectious Inoculum Preparation
2.11. In Vivo Phage Therapy (Mouse Model)
2.12. Bacterial Cell Counting and Detection of Cytokines
2.13. Histopathological Analysis
2.14. Statistical Analysis
3. Results
3.1. Morphology of Phages
3.2. Phage Host Range
3.3. Optimal Multiplicity of Infection
3.4. One-Step Growth Curve
3.5. Phage Genome Identification
3.6. Growth Kinetic Curve of In Vitro Lysis
3.7. The Ability of Phages to Remove Biofilms
3.8. Colony-Forming Units
3.9. Changes in TNF-α and IL-6 Concentrations
3.10. Histopathological Analysis
4. Discussion
5. Conclusions
Author Contributions
Funding
Institutional Review Board Statement
Informed Consent Statement
Data Availability Statement
Conflicts of Interest
References
- Da Silva Duarte, V.; Dias, R.S.; Kropinski, A.M.; Campanaro, S.; Treu, L.; Siqueira, C.; Vieira, M.S.; Da Silva Paes, I.; Santana, G.; Martins, F.; et al. Genomic analysis and immune response in a murine mastitis model of vB_EcoM-UFV13, a potential biocontrol agent for use in dairy cows. Sci. Rep. 2018, 8, 6845. [Google Scholar] [CrossRef] [PubMed]
- Leitner, G.; Lubashevsky, E.; Trainin, Z. Staphylococcus aureus vaccine against mastitis in dairy cows, composition and evaluation of its immunogenicity in a mouse model. Vet. Immunol. Immunopathol. 2003, 93, 159–167. [Google Scholar] [CrossRef]
- Avedissian, S.N.; Rhodes, N.J.; Shaffer, C.L.; Tran, L.; Bradley, J.S.; Le, J. Antimicrobial prescribing for treatment of serious infections caused by Staphylococcus aureus and methicillin-resistant Staphylococcus aureus in pediatrics: An expert review. Expert Rev. Anti-Infect. Ther. 2021, 19, 1107–1116. [Google Scholar] [CrossRef] [PubMed]
- Toledo-Silva, B.; de Souza, F.N.; Mertens, K.; Piepers, S.; Haesebrouck, F.; De Vliegher, S. Bovine-associated non-aureus staphylococci suppress Staphylococcus aureus biofilm dispersal in vitro yet not through agr regulation. Vet. Res. 2021, 52, 114. [Google Scholar] [CrossRef] [PubMed]
- Tong, S.; Davis, J.; Eichenberger, E.; Holland, T.; Fowler, V. Staphylococcus aureus infections: Epidemiology, pathophysiology, clinical manifestations, and management. Clin. Microbiol. Rev. 2015, 28, 603–661. [Google Scholar] [CrossRef] [PubMed]
- Breyne, K.; Honaker, R.; Hobbs, Z.; Richter, M.; Zaczek, M.; Spangler, T.; Steenbrugge, J.; Lu, R.; Kinkhabwala, A.; Marchon, B.; et al. Efficacy and Safety of a Bovine-Associated Staphylococcus aureus Phage Cocktail in a Murine Model of Mastitis. Front. Microbiol. 2017, 8, 2348. [Google Scholar] [CrossRef]
- Guo, Y.; Song, G.; Sun, M.; Wang, J.; Wang, Y. Prevalence and Therapies of Antibiotic-Resistance in Staphylococcus aureus. Front. Cell. Infect. Microbiol. 2020, 10, 107. [Google Scholar] [CrossRef]
- Menichetti, F.; Tagliaferri, E. Antimicrobial resistance in internal medicine wards. Intern. Emerg. Med. 2012, 7, 271–281. [Google Scholar] [CrossRef]
- Mediavilla, J.R.; Chen, L.; Mathema, B.; Kreiswirth, B.N. Global epidemiology of community-associated methicillin resistant Staphylococcus aureus (CA-MRSA). Curr. Opin. Microbiol. 2012, 15, 588–595. [Google Scholar] [CrossRef]
- Lakhundi, S.; Zhang, K. Methicillin-Resistant Staphylococcus aureus: Molecular Characterization, Evolution, and Epidemiology. Clin. Microbiol. Rev. 2018, 31, e00020-18. [Google Scholar] [CrossRef]
- Lin, S.; Koh, J.-J.; Aung, T.; Sin, W.L.W.; Lim, F.; Wang, L.; Lakshminarayanan, R.; Zhou, L.; Tan, D.T.H.; Cao, D.; et al. Semisynthetic Flavone-Derived Antimicrobials with Therapeutic Potential against Methicillin-Resistant Staphylococcus aureus (MRSA). J. Med. Chem. 2017, 60, 6152–6165. [Google Scholar] [CrossRef]
- Shlezinger, M.; Khalifa, L.; Houri-Haddad, Y.; Coppenhagen-Glazer, S.; Resch, G.; Que, Y.-A.; Beyth, S.; Dorfman, E.; Hazan, R.; Beyth, N. Phage Therapy: A New Horizon in the Antibacterial Treatment of Oral Pathogens. Curr. Top. Med. Chem. 2017, 17, 1199–1211. [Google Scholar] [CrossRef]
- Krut, O.; Bekeredjian-Ding, I. Contribution of the Immune Response to Phage Therapy. J. Immunol. 2018, 200, 3037–3044. [Google Scholar] [CrossRef]
- Rios, A.C.; Moutinho, C.; Pinto, F.C.; Fiol, F.D.S.D.; Jozala, A.; Chaud, M.V.; Vila, M.M.; Teixeira, J.; Balcão, V.M. Alternatives to overcoming bacterial resistances: State-of-the-art. Microbiol. Res. 2016, 191, 51–80. [Google Scholar] [CrossRef]
- Schmelcher, M.; Powell, A.M.; Camp, M.J.; Pohl, C.S.; Donovan, D.M. Synergistic streptococcal phage λSA2 and B30 endolysins kill streptococci in cow milk and in a mouse model of mastitis. Appl. Microbiol. Biotechnol. 2015, 99, 8475–8486. [Google Scholar] [CrossRef]
- Gill, J.J.; Pacan, J.C.; Carson, M.E.; Leslie, K.E.; Griffiths, M.W.; Sabour, P.M. Efficacy and Pharmacokinetics of Bacteriophage Therapy in Treatment of Subclinical Staphylococcus aureus Mastitis in Lactating Dairy Cattle. Antimicrob. Agents Chemother. 2006, 50, 2912–2918. [Google Scholar] [CrossRef]
- Moscoso, M.; Suárez, J. Characterization of the DNA replication module of bacteriophage A2 and use of its origin of replication as a defense against infection during milk fermentation by Lactobacillus casei. Virology 2000, 273, 101–111. [Google Scholar] [CrossRef]
- Zago, M.; Lanza, B.; Rossetti, L.; Muzzalupo, I.; Carminati, D.; Giraffa, G. Selection of Lactobacillus plantarum strains to use as starters in fermented table olives: Oleuropeinase activity and phage sensitivity. Food Microbiol. 2013, 34, 81–87. [Google Scholar] [CrossRef]
- Gutiérrez, D.; Rodríguez-Rubio, L.; García, P.; Billington, C.; Premarante, A.; Rodríguez, A.; Martínez, B. Phage sensitivity and prophage carriage in Staphylococcus aureus isolated from foods in Spain and New Zealand. Int. J. Food Microbiol. 2016, 230, 16–20. [Google Scholar] [CrossRef]
- Ung, P.; Peng, C.; Yuk, S.; Ann, V.; Mith, H.; Tan, R.; Miyanaga, K.; Tanji, Y. Fate of Escherichia coli in dialysis device exposed into sewage influent and activated sludge. J. Water Health 2018, 16, 380–390. [Google Scholar] [CrossRef]
- Peng, C.; Hanawa, T.; Azam, A.H.; LeBlanc, C.; Ung, P.; Matsuda, T.; Onishi, H.; Miyanaga, K.; Tanji, Y. Silviavirus phage ΦMR003 displays a broad host range against methicillin-resistant Staphylococcus aureus of human origin. Appl. Microbiol. Biotechnol. 2019, 103, 7751–7765. [Google Scholar] [CrossRef]
- Geng, H.; Zou, W.; Zhang, M.; Xu, L.; Liu, F.; Li, X.; Wang, L.; Xu, Y. Evaluation of phage therapy in the treatment of Staphylococcus aureus-induced mastitis in mice. Folia Microbiol. 2020, 65, 339–351. [Google Scholar] [CrossRef]
- Iwano, H.; Inoue, Y.; Takasago, T.; Kobayashi, H.; Furusawa, T.; Taniguchi, K.; Fujiki, J.; Yokota, H.; Usui, M.; Tanji, Y.; et al. Bacteriophage ΦSA012 Has a Broad Host Range against Staphylococcus aureus and Effective Lytic Capacity in a Mouse Mastitis Model. Biology 2018, 7, 8. [Google Scholar] [CrossRef]
- Naghili, H.; Tajik, H.; Mardani, K.; Rouhani, S.M.R.; Ehsani, A.; Zare, P. Validation of drop plate technique for bacterial enumeration by parametric and nonparametric tests. Veter. Res. Forum Int. Q. J. 2013, 4, 179–183. [Google Scholar]
- Deghorain, M.; Van Melderen, L. The Staphylococci Phages Family: An Overview. Viruses 2012, 4, 3316–3335. [Google Scholar] [CrossRef]
- Cha, Y.; Chun, J.; Son, B.; Ryu, S. Staphylococcus aureus Characterization and Genome Analysis of Podovirus CSA13 and Its Anti-Biofilm Capacity. Viruses 2019, 11, 54. [Google Scholar] [CrossRef]
- Barros, J.; Melo, L.; Poeta, P.; Igrejas, G.; Ferraz, M.P.; Azeredo, J.; Monteiro, F. Lytic bacteriophages against multidrug-resistant Staphylococcus aureus, Enterococcus faecalis and Escherichia coli isolates from orthopaedic implant-associated infections. Int. J. Antimicrob. Agents 2019, 54, 329–337. [Google Scholar] [CrossRef]
- Lewis, R.; Clooney, A.G.; Stockdale, S.R.; Buttimer, C.; Draper, L.A.; Ross, R.P.; Hill, C. Isolation of a Novel Jumbo Bacteriophage Effective against Klebsiella aerogenes. Front. Med. 2020, 7, 67. [Google Scholar] [CrossRef]
- Azeredo, F.J. Use of newly isolated phages for control of Pseudomonas aeruginosa PAO1 and ATCC 10145 biofilms. Res. Microbiol. 2011, 162, 798–806. [Google Scholar]
- Milho, C.; Andrade, M.; Boas, D.V.; Alves, D.; Sillankorva, S. Antimicrobial assessment of phage therapy using a porcine model of biofilm infection. Int. J. Pharm. 2019, 557, 112–123. [Google Scholar] [CrossRef]
- Barkema, H.; Schukken, Y.; Zadoks, R. Invited Review: The Role of Cow, Pathogen, and Treatment Regimen in the Therapeutic Success of Bovine Staphylococcus aureus Mastitis. J. Dairy Sci. 2006, 89, 1877–1895. [Google Scholar] [CrossRef]
- Notebaert, S.; Meyer, E. Mouse models to study the pathogenesis and control of bovine mastitis. A review. Veter. Q. 2006, 28, 2–13. [Google Scholar] [CrossRef] [PubMed]
- Omwenga, I.; Aboge, G.O.; Mitema, E.S.; Obiero, G.; Ngaywa, C.; Ngwili, N.; Wamwere, G.; Wainaina, M.; Bett, B. Antimicrobial Usage and Detection of Multidrug-Resistant Staphylococcus aureus, Including Methicillin-Resistant Strains in Raw Milk of Livestock from Northern Kenya. Microb. Drug Resist. 2020, 27, 843–854. [Google Scholar] [CrossRef] [PubMed]
- De Lencastre, H.; Oliveira, D.; Tomasz, A. Antibiotic resistant Staphylococcus aureus: A paradigm of adaptive power. Curr. Opin. Microbiol. 2007, 10, 428–435. [Google Scholar] [CrossRef] [PubMed]
- Zhao, L.; Guo, Z.; Liu, J.; Wang, Z.; Wang, R.; Li, Y.; Wang, L.; Xu, Y.; Tang, L.; Qiao, X. Recombinant Lactobacillus casei expressing Clostridium perfringens toxoids α, β2, ε and β1 gives protection against Clostridium perfringens in rabbits. Vaccine 2017, 35, 4010–4021. [Google Scholar] [CrossRef]
- Maskrey, B.H.; Megson, I.L.; Whitfield, P.D.; Rossi, A.G. Mechanisms of resolution of inflammation: A focus on cardiovascular disease. Arterioscler. Thromb. Vasc. Biol. 2011, 31, 1001–1006. [Google Scholar] [CrossRef] [PubMed]

| Phage 4086-1 | Phage 4086-2 | Phage 4086-3 | Phage 4086-4 | Phage 4086-6 | |
|---|---|---|---|---|---|
| S. aureus CVCC 546 | + | + | + | + | + |
| S. aureus 4086 | + | + | + | + | + |
| S. aureus Ben | + | + | + | − | − |
| S. aureus ATCC 43,300 | + | + | + | − | − |
| Micrococcus luteus 26,003 | − | − | − | − | − |
| Staphylococcus saparophytics 17 | − | − | − | − | − |
| Staphylococcus saparophytics E4 | − | − | − | − | − |
| Staphylococcus saparophytics X4 | − | − | − | − | − |
| Staphylococcus haemolyticus 13 | − | − | − | − | − |
| Staphylococcus xylosus 17 | − | − | − | − | − |
| Enterococcus faecalis 13 | − | − | − | − | − |
| Bacillus subtilis | − | − | − | − | − |
| Pasteurella p−1059 | − | − | − | − | − |
| Staphylococcus gallinarum CVCC 528 | − | − | − | − | − |
| Escherichia coli BL 21 | − | − | − | − | − |
| Escherichia coli DH5α | − | − | − | − | − |
| Escherichia coli CVCC 10,141 | − | − | − | − | − |
| Total | 4 | 4 | 4 | 2 | 2 |
Publisher’s Note: MDPI stays neutral with regard to jurisdictional claims in published maps and institutional affiliations. |
© 2022 by the authors. Licensee MDPI, Basel, Switzerland. This article is an open access article distributed under the terms and conditions of the Creative Commons Attribution (CC BY) license (https://creativecommons.org/licenses/by/4.0/).
Share and Cite
Teng, F.; Xiong, X.; Zhang, S.; Li, G.; Wang, R.; Zhang, L.; Wang, X.; Zhou, H.; Li, J.; Li, Y.; et al. Efficacy Assessment of Phage Therapy in Treating Staphylococcus aureus-Induced Mastitis in Mice. Viruses 2022, 14, 620. https://doi.org/10.3390/v14030620
Teng F, Xiong X, Zhang S, Li G, Wang R, Zhang L, Wang X, Zhou H, Li J, Li Y, et al. Efficacy Assessment of Phage Therapy in Treating Staphylococcus aureus-Induced Mastitis in Mice. Viruses. 2022; 14(3):620. https://doi.org/10.3390/v14030620
Chicago/Turabian StyleTeng, Fei, Xiaoyu Xiong, Songsong Zhang, Guiwei Li, Ruichong Wang, Lanlan Zhang, Xiaona Wang, Han Zhou, Jiaxuan Li, Yijing Li, and et al. 2022. "Efficacy Assessment of Phage Therapy in Treating Staphylococcus aureus-Induced Mastitis in Mice" Viruses 14, no. 3: 620. https://doi.org/10.3390/v14030620
APA StyleTeng, F., Xiong, X., Zhang, S., Li, G., Wang, R., Zhang, L., Wang, X., Zhou, H., Li, J., Li, Y., Jiang, Y., Cui, W., Tang, L., Wang, L., & Qiao, X. (2022). Efficacy Assessment of Phage Therapy in Treating Staphylococcus aureus-Induced Mastitis in Mice. Viruses, 14(3), 620. https://doi.org/10.3390/v14030620
